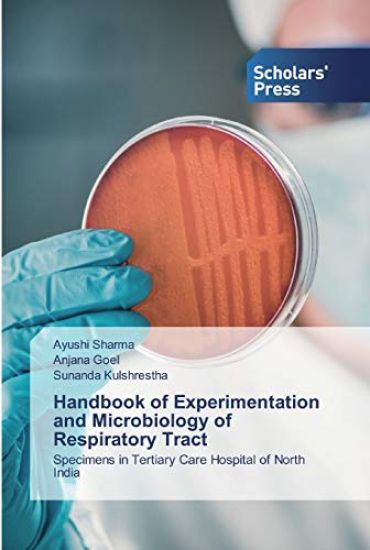
Handbook of Experimentation and Microbiology of Respiratory Tract

Kirjahaku
Etsi kirjoja tekijän nimen, kirjan nimen tai ISBN:n perusteella.
386 tulosta hakusanalla Ayush Sharma


Immunological Disorders of the oral cavity
Ayush Gupta; Sanjeet Singh; Kanika Sharma
Lap Lambert Academic Publishing
2022
nidottu

Immunologische Störungen in der Mundhöhle
Ayush Gupta; Sanjeet Singh; Kanika Sharma
Verlag Unser Wissen
2022
nidottu

Trastornos inmunológicos de la cavidad oral
Ayush Gupta; Sanjeet Singh; Kanika Sharma
Ediciones Nuestro Conocimiento
2022
nidottu

Troubles immunologiques de la cavité buccale
Ayush Gupta; Sanjeet Singh; Kanika Sharma
Editions Notre Savoir
2022
nidottu

Disturbi immunologici del cavo orale
Ayush Gupta; Sanjeet Singh; Kanika Sharma
Edizioni Sapienza
2022
nidottu

Perturbações imunológicas da cavidade oral
Ayush Gupta; Sanjeet Singh; Kanika Sharma
Edições Nosso Conhecimento
2022
nidottu
Handbook of Experimentation and Microbiology of Respiratory Tract
Ayushi Sharma; Anjana Goel; Sunanda Kulshrestha
Scholars' Press
2020
pokkari
Respiratory tract infections are the most common kind of infections found in the population. The microbes easily get into the body through the source of air one inhales and cause infection. They are easily procurable in samples like sputum or naso-pharyngeal specimen from the person. The handbook compiles all related experimentation that will be helpful for researchers to devise the working plan to find out the type of microbial infection in the sample collected.

HBV had been arranged into eight genotypes, assigned as A-H, upheld by intergenotypic dissimilarity of at least eight percent inside the total nucleotide grouping or up to a sum of four percent inside the S gene. HBV genotypes have been found in fluctuating rates in unmistakable geological extents and consequently are identified with the force of liver contaminations and infections in particular locales.


Endodoncia guiada
Ayushi Sharma; Sachin Gupta; Vineeta Nikhil
Ediciones Nuestro Conocimiento
2023
nidottu



Endodontia guiada
Ayushi Sharma; Sachin Gupta; Vineeta Nikhil
Edicoes Nosso Conhecimento
2023
pokkari

Guided Endodontics
Ayushi Sharma; Sachin Gupta; Vineeta Nikhil
Lap Lambert Academic Publishing
2023
pokkari





